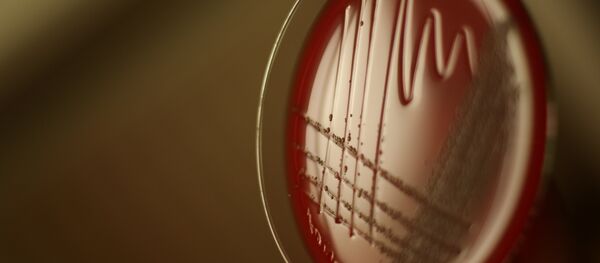
Bacteries - Sputnik Afrique

Des spéléologues américains ont retrouvé des micro-organismes dans la grotte des Cristaux située à une profondeur de 300 mètres sous la ville de Naica dans l'État mexicain de Chihuahua au nord du pays. Plus tard, la spécialiste en astrobiologie de la NASA Penelope Boston a réussi à « réveiller » dans son laboratoire ces microbes dont l'âge pourrait atteindre environ 50 000 ans. Selon Mme Boston, citée par le National Geographic, ces derniers ressemblent à des micro-organismes déjà connus et mais ils sont toutefois génétiquement différents.
D'après les scientifiques, cette découverte pourrait influencer la vision existante de l'évolution des micro-organismes sur la planète bleue.
Dans le même temps, le microbiologiste Brent Christner de l'Université de Floride considère que la possibilité de ranimer des microbes âgés de 10 à 50 000 ans n'est pas aussi irréaliste car ils pouvaient parfaitement vivre dans un isolement complet du monde extérieur en se nourrissant des restes de leurs congénères.
Néanmoins, le National Geographic prévient que les résultats de ces recherches n'ayant pas encore été confirmés, il faut rester prudent sur ce sujet.
La grotte des Cristaux doit son nom à la possibilité d'abriter des cristaux géants de sélénite, une variété de gypse, dans sa salle principale. Ils comptent parmi les plus grands cristaux naturels du monde avec le plus grand exemplaire mesurant 12 mètres de longueur et 4 mètres de diamètre pour un poids de 55 tonnes. La température de la grotte peut atteindre 58 °C avec une hygrométrie de 90 à 99 % ce qui ne permet pas d'y rester plus de dix minutes. Bien que cette atmosphère constitue une entrave à son exploration, elle la protège aussi de dégradations humaines.
Suivez Sputnik sur Telegram pour ne jamais manquer les actualités les plus importantes grâce à nos sélections du matin et du soir. Pour recevoir les actualités de notre chaîne, il suffit de télécharger l'application Telegram sur n'importe quel smartphone, tablette ou ordinateur puis cliquer sur le lien et appuyer sur « Join ».